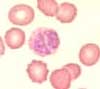

Ausstrich zu dünn

Zu dünne Ausstriche entstehen, wenn beim Ausstreichen zu viel Druck ausgeübt oder ein zu kleiner Blutstropfen verwendet wird. Ist der Ausstrich zu dünn, so weisen die Erythrozyten keine Delle auf und sind oft polygonal geformt und aneinander gelagert. Somit ist hier insbesondere die Morphologie der Erythrozyten nicht beurteilbar.
Ausstrich zu dick

Zu dicke Ausstriche entstehen, wenn beim Ausstreichen zu wenig Druck ausgeübt oder ein zu grosser Blutstropfen verwendet wird. Ist der Ausstrich zu dick, so sind die Erythrozyten übereinander gelagert und es kommt oft zur Pseudo-Geldrollenbildung. Dieses Phänomen ist in diesem Zusammenhang weit häufiger als im Rahmen eines Multiplen Myeloms, wo eine "echte" Geldrollenbildung vorkommt. Auch hier ist insbesondere die Morphologie der Erythrozyten nicht beurteilbar.
Färbung zu sauer
Die Pufferlösung für die May-Grünwald-Giemsa-Färbung sollte einen pH-Wert zwischen 6.5 und 6.8 aufweisen. Ist sie zu sauer, so werden die Erythrozyten stark oxyphil und die Leuozyten sind schlecht angefärbt. Somit sind hier insbesondere die Leukozyten nicht beurteilbar
Färbung zu alkalisch

Die Pufferlösung für die May-Grünwald-Giemsa- Färbung sollte einen pH-Wert zwischen 6.5 und 6.8 aufweisen. Ist sie zu alkalisch, so werden die Erythrozyten stark basophil und die Leukozyten erhalten ein toxisches Aussehen mit verstärkter Granulation und blauem Zytoplasma.
Lädierte Leukozyten, insbesondere bei Hyperlipidämie

Wird beim Ausstreichen zu viel Druck angewandt, können Leukozyten lädiert werden und sind nicht mehr beurteilbar. Beim Vorliegen einer Hyperlipidämie platzen die Leukozyten auch bei korrekt erstelltem Ausstrich. Die Durchführung einer mikroskopischen Leukozyten-Differenzierung ist darum nicht möglich. Bei der chronischen lymphatischen Leukämie (CLL) sind die leukämischen Zellen auch leicht lädierbar. Sie werden Gumprecht'sche Schollen genannt und sind ein typisches Merkmal der CLL.
Pseudoeinschlüsse

Beim Trocknen der Ausstriche können kleine Verdichtungen entstehen, die wie Einschlüsse in den Erythrozyten aussehen. Sie sind am ehesten mit Pappenheimer Körperchen zu verwechseln. Durch drehen an der Mikrometerschraube werden diese Pseudoeinschlüsse (links im Bild) im Gegensatz zu echten Einschlüssen (rechts im Bild) zu Aufhellungen.
Zu späte Verarbeitung

EDTA-Blut muss für die mikroskopische Beurteilung innerhalb von 2 Stunden nach Blutentnahme verarbeitet werden. Verstreicht mehr Zeit, so treten bei den Leukozyten verschiedene Veränderungen auf. Es sind dies in erster Linie Vakuolen und vergröberte Granulation, sodass diese ein toxisches Blutbild vortäuschen. Eine ganz typische und unverwechselbare Erscheinung ist die Leukolyse. Hierbei kommt es zu charakteristischen Veränderungen des Zellkerns in Form von Abspaltungen und runden Verdichtungen. Bei solitärem dichtem rundem Kern ist eine Verwechslung mit Normoblasten möglich.
Zu warme Lagerung

Wird das Blut nach der Entnahme zu warm (mehr als Zimmertemperatur) gelagert, kann es zu einer kleeartigen Lappung des Kerns der Lymphozyten kommen.